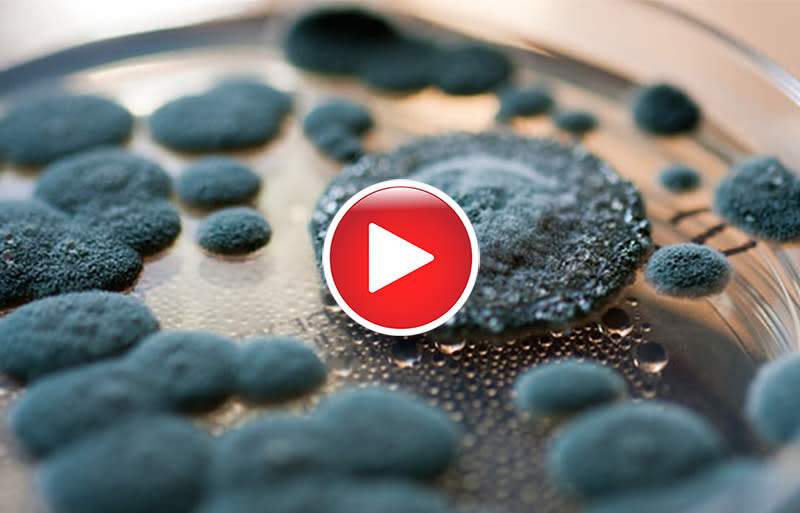

Managing Mold (On-Demand Video)
Thursday, December 31, 2020
Description

Panelists will discuss the builder defect dilemma, and how to manage mold!
Panelists:
- Toner Kersting - TONER Home Matters
- Brian Wright - Crossway Mechanical
- Jason Adams - Prime 1 Consulting
Sponsored By:

Thursday, December 31, 2020
Registered Guests
1
1
Powered By GrowthZone
